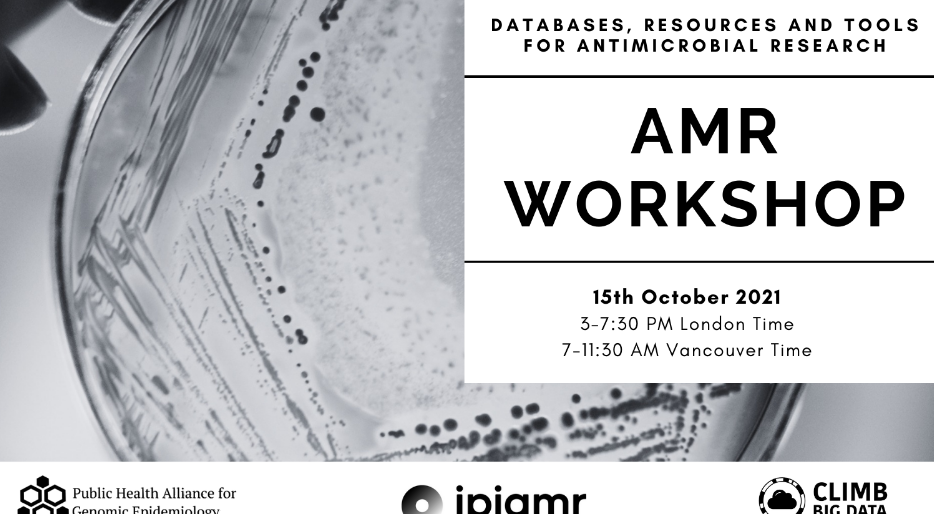
AMR WORKSHOP 1 amr workshop

AMR WORKSHOP
AMR WORKSHOP telah menciotai namanya sebagai destinasi utama bagi peminat automotif di Pontian, Johor. Khusus dalam dunia ekzos kenderaan, bengkel ini menonjol kerana komitmen terhadap kualiti kerja dan kepuasan pelanggan. Dengan pasukan teknikal yang berpengalaman, mereka menawarkan perkhidmatan lengkap dari pemasangan sistem ekzos baharu hingga penyelesaian masalah performa. Terletak di Kedai Exhaust di Malaysia, AMR WORKSHOP bukan sekadar bengkel biasa, ia adalah pusat bagi mereka yang menghargai bunyi ekzos yang mantap dan peningkatan kecekapan enjin. Reputasi mereka dibina atas dasar kepakaran dan perkhidmatan yang boleh dipercayai.
T/L 25 KAMPUNG PERMATANG SEPAM BENUT, 82210 PONTIAN, Johor Darul Ta'zim, Malaysia
+60 11-2785 3343
AMR WORKSHOP di T/L 25 Kampung Permatang Sepam, Benut merupakan pilihan utama untuk pemilik kenderaan yang mencari servis ekzos berkualiti di Johor. Dengan kepakaran dalam pemasangan dan modifikasi sistem ekzos, bengkel ini dikenal pasti memberikan hasil kerja yang memuaskan dan peningkatan prestasi yang ketara. Lokasi yang mudah diakses dan perkhidmatan yang profesional menjadikannya sangat disyorkan, sebagaimana dibuktikan oleh rating lima bintang yang diterima. Pastikan untuk menghubungi +60 11-2785 3343 untuk sebarang pertanyaan atau temujanji.
| Khamis | 8:00 PGโ8:00 PTG |
| Jumaat | 8:00 PGโ8:00 PTG |
| Sabtu | 8:00 PGโ8:00 PTG |
| Ahad | 8:00 PGโ8:00 PTG |
| Isnin | 8:00 PGโ8:00 PTG |
| Selasa | 8:00 PGโ8:00 PTG |
| Rabu | 8:00 PGโ8:00 PTG |
Maklumat lanjut
Apakah yang ditawarkan oleh AMR WORKSHOP?
AMR WORKSHOP adalah kedai exhaust khusus yang menawarkan perkhidmatan lengkap untuk sistem ekzos kenderaan anda. Kami menyediakan pelbagai perkhidmatan termasuk pemasangan, tuning, dan penjualan pelbagai jenis exhaust serta komponen berkaitan untuk meningkatkan prestasi kenderaan.
Di manakah lokasi AMR WORKSHOP?
AMR WORKSHOP beroperasi di T/L 25 Kampung Permatang Sepam, Benut, 82210 Pontian, Johor. Lokasi kedai kami yang strategik memudahkan pelanggan dari sekitar Johor Darul Ta’zim untuk mendapatkan perkhidmatan exhaust yang berkualiti.
Bagaimana untuk menghubungi AMR WORKSHOP?
Anda boleh menghubungi kami melalui nombor telefon +60 11-2785 3343 untuk sebarang pertanyaan, membuat tempahan, atau mendapatkan konsultasi percuma mengenai keperluan exhaust kenderaan anda.
Adakah perkhidmatan di AMR WORKSHOP mendapat penilaian baik?
Ya, AMR WORKSHOP sangat komited dengan kualiti perkhidmatan dan telah menerima penilaian 5 bintang daripada ramai pelanggan yang berpuas hati dengan hasil kerja dan produk exhaust yang ditawarkan.





